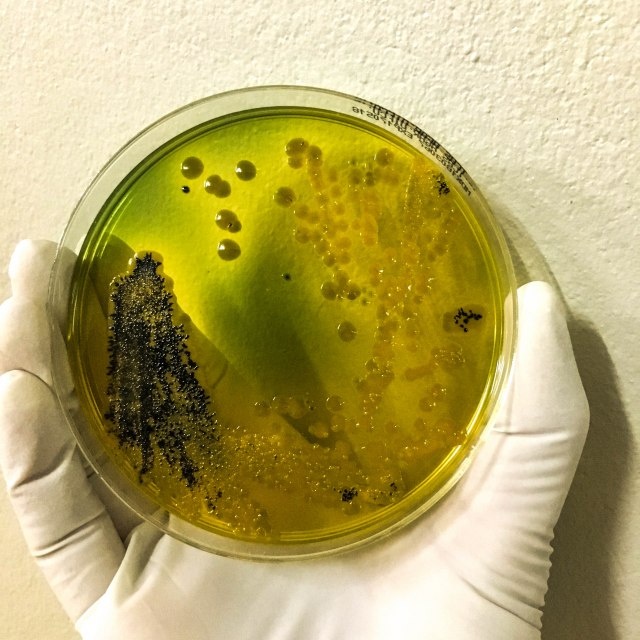

Autoritetet kineze kanë njoftuar se një student në Wuhan është infektuar me kolerë, ndërsa është bërë e ditur se ky lloj bakteri që shkakton sëmundje infektive u gjet në një breshkë që shitet në treg.
Megjithëse infeksioni i kolerës së studentit nuk ka qenë i lidhur me breshkën e infektuar, autoritetet shëndetësore kanë mbyllur një tezgë tregu në zonën e Baishaju ku shiten breshkat me gëzhoja të buta. Më pas tregu u dezinfektua dhe të gjithë ata që ranë në kontakt me breshkat u testuan, shkruan Reuters, transmeton portal arbresh.info
Megjithëse nuk ka indikacione të qarta për një epidemi kolere, qytetarët në qytetin kinez ku shpërtheu fillimisht koronavirusi janë të shqetësuar, gjë që ilustrohet më së miri nga fakti se një mikroblog me këtë temë në rrjetin social Weibo, homologu kinez i Tëitter, kishte 200 milion shikime.
Ankthi i popullit kinez për kolerën është mjaft i kuptueshëm duke pasur parasysh pandeminë e koronavirusit SARS-CoV-2, e cila nisi marshimin e saj vdekjeprurës nëpër botë pikërisht nga Ëuhan, ku shpërthyen rastet e para të sëmundjes Covid-19 në nëntor 2019 dhe ishin të lidhur me tregun Huanan.
Megjithatë, edhe pas dy vitesh e gjysmë që nga shfaqja e koronavirusit të ri, origjina e tij nuk është sqaruar plotësisht: ka mundësi që të bëhet fjalë për evolucionin natyror të një virusi, të afërmit e të cilit kanë bërë një shtëpi në lakuriq nate, por janë shfaqur zëra që koronavirusi edhe mund të ketë dalë nga laboratori.
Lidhur me rastin e kolerës, Universiteti Ëuhan njoftoi të hënën se një student me simptoma si ethe, të vjella dhe diarre u shtrua në spitalin universitar më 8 korrik. Studenti u dërgua në spital dhe aktualisht ndodhet në izolim. Studenti më pas u diagnostikua me shtamin e kolerës 0139.
Kolera është një sëmundje infektive e zorrës së hollë e shkaktuar nga bakteri Vibrio cholerae. Simptomat, të cilat fillojnë një deri në tre ditë pas infektimit me bakteret, variojnë nga një episod i lehtë i pakomplikuar i diarresë deri te një sëmundje e rëndë që mund të çojë në vdekje./arbresh.info/
Edhe emocionet e lumtura mund të shkaktojnë të ngrënit e tep...
“Përshkallëzim i rrezikshëm”, Emiratet e Bashkuara Arabe: Tr...
Barcelona e pandalshme në ‘Camp Nou’, mposht Betisin
Mexhiti i VLEN reagon disa orë para protestës: Provimi i jur...
Qendra Sociale në Fushë Kosovë me nevojë urgjente për staf
Ultimatumi i ri i Trumpit ndaj Iranit: Koha po mbaron